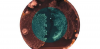

|
川口・祖父母強殺:19歳被告が手紙「貧困児童に関心を」 |
 |
涙が止まらない…『アベンジャーズ/エンドゲーム』感動的な削除シーンが公開 |
 |
リモート接客で話題のガールズバー、ボトルキープ代の先払いに対応 新型コロナの苦境に立ち向かう |
|
iPhoneが密かにハッキングされているかどうかわかるアプリが登場 |
 |
日生、三井生命を買収 3000~4000億円で株8割 |
 |
見た目はまるでタブレット?――ZTE、薄く高精細になったAndroid搭載プロジェクター「Spro Plus」を発表 |
|
【ポケモンGO】ジムバトルの基本とやり方 |
|
ユニクロに潰された数々の企業に学ぶ「変われないことの危険性」 |
 |
働く“キラキラ女子”はかっこいい――Web業界のお仕事事情を描く“ITきゅんきゅん系”漫画「彼女のいる彼氏」 |
|
キレイに見えるモノの正体は…。おへそのゴマ、実は指紋並みに個性的 |
|
不戦の理念、永久に変えてはならない 長崎平和宣言全文 |
|
繁殖実験の失敗で生まれて “グレムリン” と呼ばれた犬 / 手術の末に最高のハッピーエンドが待っていた |
 |
アジア系男性が激しい暴行で重症、NY市警が動画を公開 |
|
日本軍に漂っていた「狂気」の正体~悪魔のエリート参謀・辻政信が地獄に引きずり込んだ |
|
ブラジルでダム決壊 17人死亡、数十人行方不明 |
 |
校長が女子大生に「性経験はあるよね?」 教育実習中のセクハラ、教職を断念する学生も |
|
米大統領選を目指すヒラリー・クリントン氏、公約として「UFOとエリア51の真相を洗いざらい公開」を掲げる |
|
【韓国】セウォル号事故翌日に潜水士500人投入は嘘だった!!!実際は8人 |
 |
外骨格ロボットは「人間の能力」を拡張する若きスーパークリエーターが考えていること - 若きプロフェッショナル |
|
ウルトラマン・科特隊の通信機が現実に! Bluetooth対応“流星バッジ”いよいよ発売へ |
 |
最大半額支援の「Go Toトラベルキャンペーン」、夏休み旅行の大半も対象へ 今知っておきたいこと |
 |
JR東日本E353系量産先行車、中央本線特急用の新型車両ついに登場! 写真18枚 |
|
女児暴行逮捕 市議会に衝撃 |
 |
失われたマメジカ、ほぼ30年ぶりに発見 |
 |
囲碁:18年ぶり欧米のプロ棋士トルマネンさん 日本棋院 |
 |
17歳エンジニアがCTOに就任|JPYC開発の最高技術責任者へ |
|
「ベネチアの運河にイルカが泳いでいた」はフェイクだった。多くの人がこのニュースを信じてしまった理由とは |
|
朴一教授「在日の生活保護率は4.4%に過ぎぬ。今も23%という『在日特権』はデマ」 |
|
紛糾「老後資金2000万円不足」問題…政治家が何を言おうが明らかなのは“不都合な真実”...“ |
|
「桜を見る会」問題で「検察が動かない」理由~「詰んでいる」のは安倍首相の「説明」(郷原信郎) - 個人 - Yahoo!ニュース |
|
「会見前から怒り狂った」 蓮實重彦さん一問一答 |
 |
アパレル各社、縮む市場で「一人負け」 |
|
【検証】「ザンギ」と「唐揚げ」はどちらがウマいのか? 有名店のテイクアウトを食べ比べてみた |
|
USJ「マリオ」はハリポタ超え!!500億円超の投資規模に…関西の子供〝夏休み無料〟 東京五輪までにオープン目指す |
 |
「給料が高くて社員が辞めない中堅企業」169社 平均年収700万以上で新卒定着率8割以上対象 | 就職四季報プラスワン | 東洋経済オンライン |
 |
長さ1mの麺がすすってもすすってもカップから出続ける「日清のどん兵衛 天ぷらそば いつもより長~い長寿祈願そば」を食べてみた |
|
一橋大出身の起業家を支援する如水ベンチャーズが1号ファンドを設立 |
 |
仁和寺のラッピング広告を施した嵐電のインパクトが強すぎる「サイレントヒルの最新作かな?」「新手のスタンド能力か?」 |
|
オシャレすぎ?女性向け「餃子の王将」がオープンすると話題に |
 |
「友人置き去りにできず」 バングラ人男性も犠牲に |
|
37年でこんなに変わっていた。地球の変遷をとらえたグーグルアースの衛星画像ビフォア・アフター |
|
休職中にデリヘルの「仕事」 女性職員を懲戒処分 千葉県印西市 |
 |
「モザイク画像の解像度を64倍にする研究」が人種差別の議論に発展、非難を集めた研究者はアカウントを停止 - GIGAZINE |
|
大炎上かつ大絶賛…アメリカで一番流行っている曲の「過激さの正体」 |
|
能年玲奈「のん」に改名 |
 |
3歳女児放置死 逮捕の24歳母親へ伝えたいシングルマザーの本音「辛かったよね」 |
 |
天気:30日にかけて大雪 東京23区も積雪の恐れ |
|
ワラビスタンの18歳、大学に受かっても…就労に高い壁 |